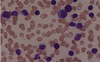

Casos clínicos hematología Flashcards
(11 cards)
A 6-year-old boy is brought to the emergency department with fever, lethargy, weight loss, scaly erythematous scalp lesions, polyuria, and painful bone swelling. A full work-up is done and including histopathological imaging. Electron micrograph from lung tissue is shown below. Which of the following pathologiesis the most likely cause of the patient’s presentation?
A) Pylocitic Astrocytoma
B) Sarcoidosis
C) Langerhans histiocytosis
D) Adamantinous Craneopharingyoma
E) Metastatic lung cancer

Langerhans histiocytosis

The tennis racket-shaped inclusions seen on blood smear are known as Birbeck granules are pathognomonic for LCH.
Langerhans cell histiocytosis (LCH) is a neoproliferative disorder of Langerhans cells, the dendritic cells of the skin the mucosa. It often involves osteolyticbone lesions and invasion of multiple organs.
The patient below has a subtype of LCH known as Hans-Schuller-Christian disease. It is associated with a triad of lytic bone lesions (often in the cranium), diabetes insipidus from primary stalkinfiltration, and exophthalmos.
A 6-year old boy comes to the emergency department because of severe bloody diarrhea and fever for 3 hours. He has been at an outdoor summer camp for several weeks. He says the last thing he ate was at dinner yesterday, but can’t remember specifically what he consumed. He is given appropriate treatment, but 4 days later he remains hospitalized after developing acute renal failure, and cutaneous petechiae. Which of the following foods is the most likely source of infection?
A) Roasted Chicken
B) Home Canned Vegetables
C) Hamburguer
D) Berries
E) Soft Boiled eggs
Hamburguer
Hemolytic-uremic syndrome (HUS) is associated with ingestion of Escherichia coli O157:H7. This pathogen is associated with undercooked beef and may result in a spectrum of illnesses, including mild diarrhea, hemorrhagic colitis with bloody diarrhea, acute renal failure, and hemolytic-uremic syndrome.
A 75 year-old man comes to the office because of progressively worsening fatigue and unintentional weight loss. He has lost 13.6-kg (30-lbs) over the past two months and his appetite is decreased. A guaiac fecal occult blood test is performed and is positive and his hematocrit is 32%. He has a past medical history of arthritis. Which of the following laboratory values is most likely to be decreased in this patient?
- Erithrocyte protoporphirin
- Serum Haptoglobin
- Serum iron
- Soluble transferrin receptor levels
- TIBC
Serum iron
Serum iron is one of the key markers of iron depletion, and can therefore be used in the diagnosis of iron deficiency anemia, along with the serum ferritin level and total iron binding capacity.
A 51-year-old woman comes to the office because of new fatigue and shortness of breath for a month. She has a history of breast cancer which was successfully treated with surgery, chemotherapy, and radiotherapy. Complete blood count shows a pancytopenia (decreased RBCs, WBCs, and platelets). A bone marrow biopsy shows hypercellular marrow. Which of the following is the most likely diagnosis?
- ß-thalasemia
- Iron deficiency
- Multiple myeloma
- MDS
- Recurrent breast cancer
MDS
Myelodysplastic syndrome can occur after cancer treatment with chemotherapy or radiotherapy. It is thought to arise from mutations in the multi-potent bone marrow stem cell, and presents with the signs and symptoms of pancytopenia.
A 3-year-old boy with Down syndrome comes to the clinic because his mother has noticed enlarged lymph nodes and easy bruising when he plays outside. He seems fatigued and irritable recently. Physical examination shows several bruises on his extremities and petechiae on his trunk. Complete blood count shows lymphopenia, anemia, and thrombocytopenia. Peripheral smear reveals the following:
- Beckwith-Wiedeman syndrome
- Type 1 NF
- Tuberous esclerosis
- Turner syndrome
- VHL disease

Type 1 NF
An increased risk of acute leukemia is associated with several genetic syndromes, including Down syndrome, Klinefelter syndrome, Li-Fraumeni syndrome, Neurofibromatosis type 1, and Fanconi anemia.
A 71-year-old man comes to the clinic because of headaches and blurry vision for the past two months. He also states that any time he grabs food out of the freezer, his fingers turn white for awhile and then blue before becoming painful and the color returning to normal. His temperature is 38.1°C (100.6°F), pulse is 78/min, respirations are 14/min, and blood pressure is 138/84 mm Hg. Physical examination shows generalized lymphadenopathy. Neurologic testing shows decreased visual acuitybilaterally. He denies pain in his extremities or back. Laboratory studies show a normal serum calciumand creatinine. Serum protein electrophoresis shows an M-spike consisting of IgM. Bone marrow aspirate (shown below) shows multiple atypical lymphocytes. Which of the following is the most likely diagnosis?
- Adult T-cell lymphoma
- Burkitt lymphoma
- Monoclonal gammopathy of uncertain significance
- Multiple myeloma
- Waldenstrom macroglobulinemia
Waldenstrom macroglobulinemia
Waldenstrom macroglobulinemia is a B-cell lymphoma characterized by the production of monoclonal IgM, which differentiates it from multiple myeloma. Symptoms are caused by hyperviscosity of the blood, manifesting as blurred vision, neurologic deficits, generalized lymphadenopathy, and Raynaud phenomenon. Diagnosis includes serum protein electrophoresis with an M spike due to IgM.
A 36-year-old woman comes to the clinic for a routine check up. She feels well but reports that she has noticed that she is bruising more easily. Medical history is noncontributory. She takes a multivitamin daily. Skin examination shows scattered petechiae on all extremities. Laboratory serum studies show a leukocyte count of 9,000/mm3, hemoglobin 12.0g/dL, platelet count 75,000/mm3, prothrombin time 12 seconds, and INR 1.0. A peripheral blood smear is obtained and is shown below. Which of the following is the most likely underlying mechanism of her condition?
- Consumption due to diffuse intravascular coagulation
- Autoimmune destruction of platelets
- Trombothic thrombocytopenic purpura
- Splenic sequestration
- Bone marrow supression

Autoimmune destruction of platelets
Idiopathic thrombocytopenic purpura (ITP) presents with epistaxis, gingival bleeding, petechiae, and easy bruising. ITP occurs secondary to autoimmune destruction of circulating platelets.
A 5-year-old boy is brought to the office because the new onset of a fine, dark, pinpoint rash most prominent over his lower legs. He was last seen two months prior with an uncomplicated upper respiratory tract infection. He has no other associated symptoms (including no fever, abdominal pain or fatigue). Physical examination shows a petechial rash and several healing bruises on his lower extremities.
Screening CBC reveals the results below:
- Leukocytes:6,500/mm3
- Hemoglobin: 13.0g/dL
- HCT:38%
- Platelets:50,000/mm3
- MCV: 96fL
- Reticulocytes:1%
- White cell differential is normal.
Which of the following is the most appropriate step in the management of this patient?
- Whole blood transfusion
- Fresh frozen plasmaTen day course of corticosteroids
- IV immunoglobulin
- Reassurence and suportive care
Reassurence and supportive care
Acute ITP in children classically occurs following a viral infection. Reassurance and supportive care and monitoring is usually all that is needed as ITP is generally benign.
A 16-year-old African American man presents to the emergency department with sudden onset of weakness, shortness of breath, and fatigue. The patient denies chest pain and his mother explains that her son had symptoms of “the common cold” for the past few days. Further discussion reveals a family history of sickle cell disease. Examination shows the patient has scleral icterus and pallor. Cardiopulmonary examination is within normal limits and abdominal exam does not reveal hepatosplenomegaly. Chest X-ray is also normal. Laboratory results show:
- Acute chest syndrome
- Aplastic anemia
- Aplastic crisis
- Hyperhemolitic crisis
- Splenic sequestration crisis

Aplastic crisis
Aplastic crisis is characterized by severe anemia and reticulocytopenia(less than 1%). In patients with sickle cell disease, aplastic crisiscommonly occurs secondary to parvovirus B19 infection. Do not confuse aplastic crisis with aplastic anemia, which is characterized by pancytopenia.
A 41-year-old woman comes to her primary care physician’s office because of fatigue and lightheadedness for the past 3 months. Physical examination shows conjunctival pallor, bilateral brisk patellar reflexes, slightly ataxic gait, and impaired position and vibration sense in the feet bilaterally. Her hematocrit is 23%. Serologic studies are positive for anti-parietal cell antibodies. What would you expect to see on peripheral blood smear?
- Codocytes
- Hypersegmented neutrophils
- Howell-Jolly bodies
- Schistocytes
- Acanthocytes
Hypersegmented neutrophils
Vitamin B12 deficiency leads to megaloblastic anemia, stomatitis, glossitis, and subacute combined degeneration of peripheral nerves and spinal cord. Blood smear will show hypersegmented neutrophils.
A 25-year-old man comes to his primary care physician because of intense generalized itching that started a month before and does not improve with over the counter creams. He also states that he has been having intermittent fevers and night sweats for the past month. He denies recent travel or sick contacts. Physical examination of the patient shows an anorexic male with non-tender lower cervical lymphadenopathy. A chest radiograph shows mediastinallymphadenopathy without masses or lesions in the lungs. Biopsy of one of the cervical lymph nodesshows scattered large binucleate cells with very prominent red nucleoli. These cells are most likely which of the following?
A) Sezary syndrome
B) Langerhans cells
C) Kupffer cells
D) Hypersegmented neutrophils
E) Reed-Sternberg cells

Reed Sternberg cells
Hodgkin lymphoma is a B-cell lymphoma characterized by the presence of Reed-Sternberg cells on lymph node biopsy, which look like scattered large binucleate cells with prominent red nucleoli.
